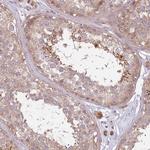
C14orf126 Antibody in Immunohistochemistry (IHC)

Search
Invitrogen
C14orf126 Polyclonal Antibody
{{$productOrderCtrl.translations['antibody.pdp.commerceCard.promotion.promotions']}}
{{$productOrderCtrl.translations['antibody.pdp.commerceCard.promotion.viewpromo']}}
{{$productOrderCtrl.translations['antibody.pdp.commerceCard.promotion.promocode']}}: {{promo.promoCode}} {{promo.promoTitle}} {{promo.promoDescription}}. {{$productOrderCtrl.translations['antibody.pdp.commerceCard.promotion.learnmore']}}
产品信息
PA5-51516
种属反应
宿主/亚型
分类
类型
抗原
偶联物
形式
浓度
规格
纯化类型
保存液
内含物
保存条件
运输条件
RRID
产品详细信息
Immunogen sequence: WVEVQRGLVI YVCFFKGADK ELLPKMVNTL LNVKLSETEN GKHVSILDLP GNILIIPQAT LGGRLKGRNM QYHSNSGKEE GFELYSQFVT LCEKEVAANS KCAEARVVVE HGTYGNRQVL KLDTNGPFTH LIFE
Highest antigen sequence identity to the following orthologs: Mouse - 84%, Rat - 85%.
靶标信息
Deacylates mischarged D-aminoacyl-tRNAs. Also deacylates mischarged glycyl-tRNA(Ala), protecting cells against glycine mischarging by AlaRS. Probably acts by rejecting L-amino acids from its binding site rather than specific recognition of D-amino acids. Catalyzes the hydrolysis of D-tyrosyl-tRNA(Tyr), has no activity on correctly charged L-tyrosyl-tRNA(Tyr). By recycling D-aminoacyl-tRNA to D-amino acids and free tRNA molecules, this enzyme counteracts the toxicity associated with the formation of D-aminoacyl-tRNA entities in vivo and helps enforce protein L-homochirality. In contrast to DTD1, deacylates L-Ala mischarged on tRNA(Thr)(G4.U69) by alanine-tRNA ligase AARS (PubMed:29410408). Can deacylate L-Ala due to a relaxed specificity for substrate chirality caused by the trans conformation of the Gly-Pro motif in the active site (PubMed:29410408). Also hydrolyzes correctly charged, achiral, glycyl-tRNA(Gly) in vitro, although in vivo EEF1A1/EF-Tu may protect cognate achiral glycyl-tRNA(Gly) from DTD2-mediated deacetylation. [UniProt]
仅用于科研。不用于诊断过程。未经明确授权不得转售。
篇参考文献 (0)
生物信息学
蛋白别名: animalia-specifc tRNA deacylase; Animalia-specific tRNA deacylase; ATD; D-aminoacyl-tRNA deacylase 2; D-tyrosyl-tRNA deacylase 2 (putative); D-tyrosyl-tRNA(Tyr) deacylase 2; L-alanyl-tRNA deacylase; probable D-tyrosyl-tRNA(Tyr) deacylase 2; putative D-tyrosyl-tRNA deacylase 2; putative D-tyrosyl-tRNA(Tyr) deacylase 2
基因别名: ATD; C14orf126; DTD2
UniProt ID: (Human) Q96FN9
Entrez Gene ID: (Human) 112487